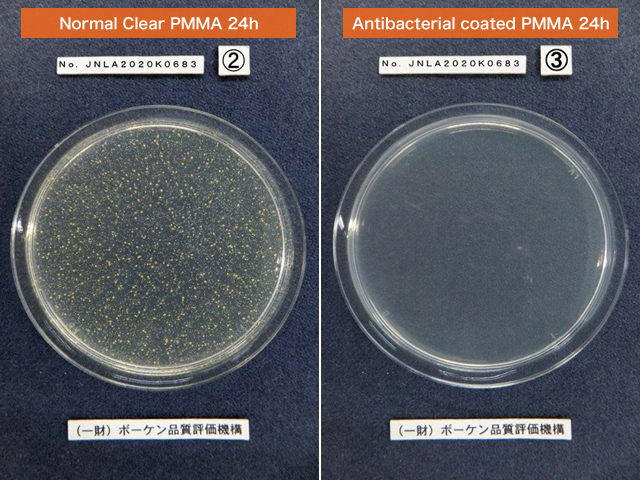
Comparison photo01

Anti-Bacteria coating on both sides
Material Code : ABS2210

PMMA Sheet with SIAA Certified Anti-Bacteria coating
It is a SIAA certified material that has passed the antibacterial and safety standards set by SIAA. Our antibacterial coat filter is allowed to display the highly reliable "SIAA mark".
Click here for the detail of SIAA certification and marks.
Protect from Infection
Antibacterial coating highly durable as it is combined with the hard-coating SIAA ※ certified antibacterial performance.
(SIAA : The Society of International sustaining growth for Antimicrobial Articles)
※ When hard-coat surface is clean and not damaged.
Strong Antibacterial Performance
The Antibacterial Index more than 2.0. (ISO 22196:2007) More than 99% of killing ratio.
Used in industry for over 20 years!!
CLAREX Anti-Bacteria Coat Filter has been in the market more than 20 years. The filter is used for the application like touch panel, medical display, and more.
- Can be cleaned with Ethanol (70%) and Sodium hypochlorite (0.1%)
- Total Light Transmittance : 90% or over
- Surface Hardness : 6H or over
No scratches after rubbing with Steel Wool (#00001)
- Touch Panel for Ticketing Machine
- Touch Panel for ATM
- Medical Display
- Medical storage box etc.
- 0.5mm~5.0mm
- 400×550mm
- 1000×1000mm
Comparison of antibacterial effect
The antibacterial effect was demonstrated in the antibacterial test by BOKEN Quality Evaluation Institute, and its performance was proved as shown in the picture below .
Staphylococcus aureus (MRSA)
Escherichia coli (E.coli)

ABS Performance
Antibacterial index of >2.0 (≧99% killing ratio) of a treated material with antimicrobial agent might be considered as "Antibacterial Article"
| Test Items | Test Method(ISO) | Antibacterial Index |
|---|---|---|
| Staphylococcus aureus | ISO 22196:2007 | 4.1 |
| Escherichia coli | 6.1 |
※ Antibacterial property can be applied to one side or both sides.





